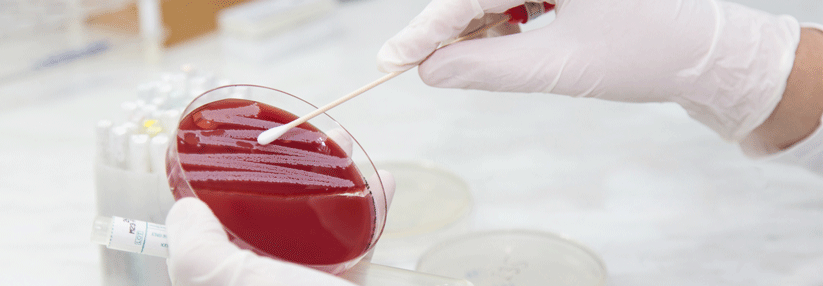
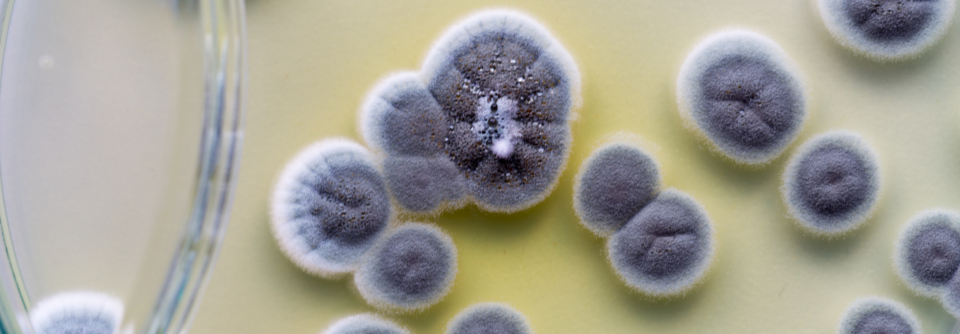
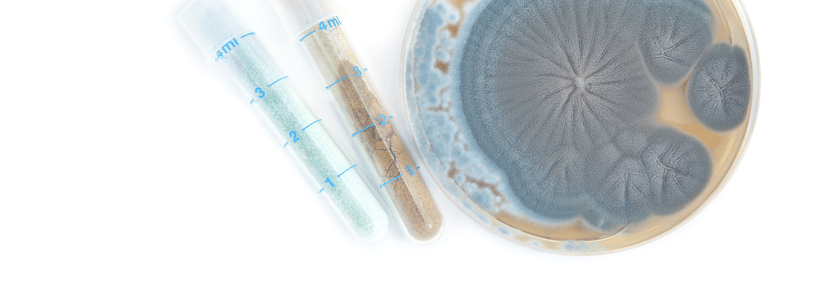

Im Rahmen unserer Website-Modernisierung arbeiten wir kontinuierlich daran, Ihnen noch bessere und aktuellere Informationen zu bieten. Diese Seite wird in Kürze mit frischen Inhalten und einem zeitgemäßen Design überarbeitet.
Arzneimittelallergie
Als Arzneimittelallergie wird eine unvorhersehbare Überempfindlichkeitsreaktion gegenüber Medikamenten bezeichnet. Sie kann sich als Sofortreaktion innerhalb von ein bis sechs Stunden nach Einnahme bemerkbar machen – die Pathophysiologie beruht hier auf einer immunologischen Reaktion mit Degranulation von Mastzellen und Basophilen.
Außerdem kennt man sogenannte Spätreaktionen, die erst mehrere Stunden oder Tage nach der Exposition auftreten. Stunden oder Tage später und beruht meist auf einem verspäteten T-Zell-abhängigen immunologischen Mechanismus. Davon abzugrenzen ist die nicht-immunologische Arzneimittelüberempfindlichkeit, bei der ein allergischer Reaktionsmechanismus nicht nachweisbar ist.
Zu den häufigsten Auslösern von Arzneimittelallergien gehören
- Antibiotika (v.a. Penicillin)
- Schmerz- und Rheumamittel
- Lokalanästhetika
- Kontrastmittel
- Psychopharmaka
- ACE-Hemmer
- Chemotherapeutika
- Epileptika
Sofortreaktionen (innerhalb von 6 Stunden):
- Flush
- Urtikaria
- Angioödem
- Konjunktivitis
- Rhinitis
- Bronchospasmus
- gastrointestinale Symptome (Übelkeit, Erbrechen, Diarrhö)
- Anaphylaxie
Typischerweise treten die Symptome hier innerhalb der ersten Stunde nach der Arzneimitteleinnahme auf.
Spätreaktionen (nach 6 Stunden):
Spätreaktionen manifestieren sich meist an der Haut.
Dazu gehören:
- generalisiertes makulopapulöses Arzneimittelexanthem
- spät auftretende oder verzögerte Urticaria
- generalisierte exanthematische Pustulose (AGEP)
- DRESS-Syndrom (Drug Rash with Eosinophilia and Systemic Symptoms): Arzneimittelexanthem mit Eosinophilie und systemischen Symptomen wie Fieber, Leberwerterhöhungen; unterschiedlicher Verlauf bis hin zur Letalität)
- Lyell-Syndrom (prgrediente Blasenbildung mit Ablösung der Epidermis)
- Stevens-Johnson-Syndrom oder toxische epidermale Nekrolyse bzw. Übergangssyndrom
- bullöses fixes Arzneimittelexanthem
Die Diagnose sollte immer über einen erfahrenen Allergologen erfolgen und beinhaltet neben der Anamnese auch standardisierte Hauttests, In-vitro- sowie Provokationstests.
Bei der Einnahme mehrere Medikamente ist die Erstellung eines Zeitstrahldiagramms zu empfehlen.
Eine falsche Klassifizierung, die nur auf der Anamnese beruht, kann Auswirkungen auf die individuelle Behandlungswahl haben und zum größeren Nachteil für die Patienten sein als eine vollständige Arzneimittelallergie-Abklärung.
Spezifische Anamnese:
Klinische Vorgeschichte (z.B. erfasst im EAACI-DAIG/ENDA Fragebogen):
- Symptomatik
- Ablauf der Symptome (vorherige Einnahme, Verzögerung zwischen letzter Dosis und dem Auftreten der Symptome, Effekt des Behandlungsabbruchs)
- andere eingenommene Medikamente (sowohl zum Zeitpunkt der Reaktion als auch seither eingenommene Medikamente der gleichen Klasse)
- medizinischer Hintergrund (einschließlich bekannter Allergien oder Neigung zu chronischer Urtikaria/chronischer Rhinosinusitis, welche sich durch die Einnahme mancher Medikamente wie z.B. ASS und NSAR verschlimmert)
Hauttests (falls standardisiert vorhanden)
- bei Soforttyp-Reaktionen Prick-Tests als erstes Screening
- bei Spätreaktionen Patch-Tests oder verzögert abgelesene Intrakutantests
Provokationstests
- Goldstandard für die Identifizierung auslösender Medikamente, bzw. den Nachweis einer Toleranz
- Orale Gabe bevorzugen
- Kontraindikationen sind lebensbedrohliche bzw. nicht kontrollierbare Arzneimittelreaktionen (z.B. schwere Hautreaktionen, Organbeteiligung, hämatologische Reaktionen)
- keine Indikation, wenn auf das Medikament in Zukunft problemlos verzichtet werden kann
- Durchführung unter höchsten Sicherheitsvorkehrung (qualifiziertes Personal, Notfall-Reanimations-Set)
Zu den häufigsten Differentialdiagnosen gehören andere Hauterkrankungen wie :
- Urtikaria
- photoallergische Dermatitis
- Purpura
- Kontaktdermatitis
- Lyell-Syndrom anderer Genese
Außerdem sollte immer ausgeschlossen werden, dass es sich nicht um Symptome der mit dem Medikament behandelten Grunderkrankung handelt.
Sofortreaktionen, vor allem wenn sie schwerwiegend sind, werden gemäß Notfallplan mit Adrenalin, Kortison und Antihistaminika behandelt.(siehe Anaphylaxie)
Außerdem muss die Einnahme aller unter Verdacht stehenden Medikamente sofort gestoppt werden.
In besonderen Situationen – wenn keine Alternative für eine lebensnotwendige Therapie bestehen – kann eine Desensibilisierungstherapie in Erwägung gezogen werden. Beispiele sind:
- Allergien gegen Tetanus-Vakzine
- Hämochromatose mit Allergie gegen Desferoxamine
- Allergien gegen notwendige Tuberkulose-Medikamente
Das oder die allergieauslösenden Medikamente sollten zukünftig gemieden werden.
Dem Patienten sollte dazu eine regelmäßig aktualisierte Beispielliste von Medikamenten, die man vermeiden soll, plus einer Liste möglicher Alternativen ausgehändigt werden.
Präventionsmaßnahmen durch Prämedikation (z.B. langsame Injektion und Vorbehandlung mit Glukocortikosteroiden und H1-Antihistaminika) sind hauptsächlich für nicht-allergische Arzneimittelreaktionen nützlich, eine IgE-vermittelte Anaphylaxie wird dadurch nicht zuverlässig unterbunden.
Siehe Anaphylaxie
Deutsche Gesellschaft für Allergologie und klinische Immunologie e.V. (DGAKI):
Leitlinie Überempfinglichkeitsreaktionen auf Arzneimittel, Allergologiosche Diagnostik
Deutsche Gesellschaft für Allergologie und klinische Immunologie e.V. (DGAKI):
Anaphylaxie, Akuttheraoie und Management
Quellen:
www.eaaci.org/ICONS/DrugAllergy/ICON_Drug_Allergy_German_web.pdf
https://www.gesundheitsinformation.de/medikamentenallergie.2950.de.html
Verschenken Sie kein Honorar: Das „Gebühren-Handbuch digital“ ist die ideale Weiterentwicklung der Printausgabe des bekannten „Medical Tribune Gebühren-Handbuchs“ - statt 2000 Buchseiten der schnelle digitale Zugriff.
Was Ihnen die Abrechnung leichter macht:
- die immer aktuelle Fassung von EBM und GOÄ (Einheitlicher Bewertungsmaßstab und Gebührenordnung für Ärzte)
- Tipps und Experten-Kommentare zur Honorarabrechnung (EBM/GOÄ), graphisch aufbereitet und leicht verständlich
- Kommentare von Kollegen lesen und selbst kommentieren
- persönliche Notizen und Lesezeichen setzen
Fortbildungen
Keine Fortbildung für diesen Fachbereich gefunden
Alle FortbildungenDiese Informationen dienen ausschließlich der Aus- und Weiterbildung von Angehörigen und Studenten der medizinischen Fachkreise (z.B. Ärzte) und enthalten nur allgemeine Hinweise. Sie dürfen nicht zur Selbstdiagnose oder -behandlung verwendet werden und sind kein Ersatz für eine ärztliche Beratung oder Behandlung. Die jeweiligen Autoren haben die Inhalte nach bestem Wissen gepflegt. Dennoch sollten Sie die Informationen stets kritisch prüfen und mit zusätzlichen Quellen vergleichen. Die Autoren und die Betreiber von medical-tribune.de übernehmen keine Haftung für Schäden, die durch nicht-kontrollierte Anwendung von Empfehlungen und Inhalten entstehen. Beiträge, die Angaben zum Einsatz und zur Dosierung von Medikamenten machen, sind die persönliche Einschätzung der Autoren. Sie ersetzen nicht die Empfehlungen des Herstellers oder des behandelnden Arztes oder Apothekers.